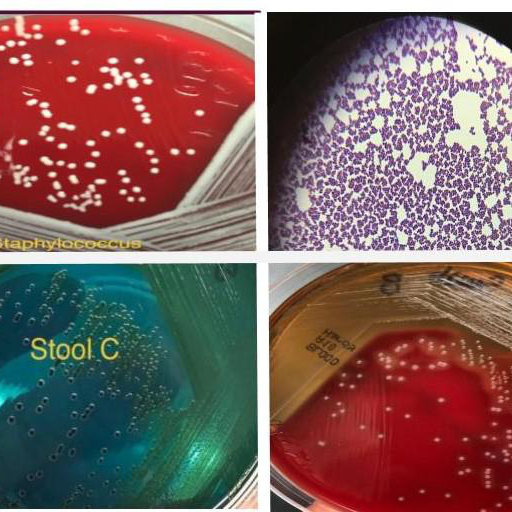
Microbiology quiz; plate reading app. icon

A great app to help you learn how to identify unknown microorganism and different types of stains.
All tests for identification of a potential pathogen is mostly based on the collection site of the specimen. This app will help you learn how to identify unknown specimen by the type of specimen the organism was isolated from.
For example, when looking at a plate collected from a urine sample, one can assume that the patient was suffering from urinary tract infection when the specimen was collected. So looking at the plate and knowing the specimen type would help in ruling out all other possible microorganism.
These key questions are very helpful in identifying unknown specimen:
1. What organisms commonly cause disease in the body site where this specimen was collected?
2. What type of medium is this organism growing on?
3. Is the medium selective?
4. If so, what does the medium select for and/or against?
5. Is the medium differential?
6. If so, what physiological characteristics does the medium distinguish?
7. What are the distinguishing features of the colonies on the plate?
8. Do these features suggest a particular organism or exclude a particular organism?
9. After addressing these questions, you should be able to narrow it down to a list of organisms that are potentially growing on the plate.
Some bacteria have unique colony characteristics, and you may be able to Identify the organism immediately, without performing any biochemical tests.
This app is free.
This app tests your knowledge of different types of stains, parts of microscope, site plate reading, mediums and more.
50 level.
Free coins;
New users will receive 50 free coins.
For correct answer user will receive 10 free coins.
User receives 20 free coins from post / tweet:
Great app to learn how to identify unknown microorganism and to master different types of stains and biochemical tests. .




